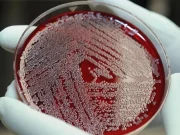
Мікропластик вдалося виявити навіть у крові людини

Вчені розробили новий спосіб лікування депресії
Наявні в даний час антидепресанти мають неприємні побічні ефекти, викликають звикання або можуть викликати шизофренію. Таким чином, розробка швидкодіючих препаратів для лікування депресії без...
Чому важливо регулярно контролювати артеріальний тиск вдома
Пацієнти з високим кров'яним тиском (гіпертонія), які контролюють артеріальний тиск вдома, краще контролюють свій стан, згідно з дослідженням, представленим в Європейському товаристві гіпертонії в...
Чому не потрібно виключати картоплю з дієти
Нове дослідження Університету Едіт Кован (ECU) показало, що, хоча картопля може не мати тих самих переваг, що й деякі інші овочі, наприклад, знижуючи ризик...
Розроблено спрей, що захищає харчові продукти від зараження та інфекцій
Дослідники розробили спосіб змусити бактеріофаги-нешкідливі віруси, які поїдають бактерії – з'єднуватися разом і утворювати мікроскопічні кульки. Ці кульки можна безпечно наносити на продукти харчування...
Мікропластик вдалося виявити навіть у крові людини
На жаль, досліджень потенційної небезпеки мікропластику для здоров'я людини не так вже й багато.
У дослідженні, опублікованому в журналі Environment International, вчені вперше розробили метод...
Вітамін D не захищає від респіраторних інфекцій, але може полегшити їх
Добровольці, які приймали вітамін D, відчували менше симптомів грипу та застуди.
У новому дослідженні, опублікованому в журналі The Lancet Diabetes and Endocrinology, вчені проаналізували дані...
В яких випадках липовий чай стає небезпечний для здоров’я
Відомо, що липа дуже корисна для організму і її рекомендується вживати взимку. Однак доктор Хусейн Ашкин Акполат зазначає, що липовий чай може іноді і...
Доведено: через переїдання у вас може виникнути інфаркт
Їсти потрібно в помірних кількостях. Також тому, що переїдання може призвести до серцевого нападу.
У Новий рік і на Різдво люди нерідко з'їдають більше, ніж...
Ці 10 продуктів допоможуть вам схуднути до зимових свят
Взимку важливо підтримувати себе у формі, особливо в новорічні свята. І в цьому можуть допомогти наступні продукти.
Спеціаліст з харчування Стефані Йейтс з Bulk.com назвала...
Вчені довели користь винограду для здоров’я шкіри людини
Виноград містить сотні потенційних фітохімікатів, які мають багато переваг для здоров'я. Наприклад, він містить невелику кількість ресвератролу, хіміопрофілактика раку. Крім того, він позитивно впливає...
Дослідження показало більш високий рівень захворюваності на рак серед співробітників м’ясної промисловості
Дослідження, проведене за участю понад 6600 працівників м'ясної промисловості по всій Новій Зеландії, виявило значно високий рівень онкологічних захворювань, особливо раку легенів, який може...
Шоколад корисний для вашого серця – повідомляють вчені
Вчені UCSF опублікували солодкі результати дослідження, що вивчають вплив шоколаду на функцію кровоносних судин у здорових людей. Команда повідомляє, що невеликі щоденні дози насиченого...
Жінки з низьким гемоглобіном мають підвищений ризик розвитку серцевого нападу
Жінки з болем у грудях, які мають низький рівень гемоглобіну, частіше страждають на серцевий напад, серцеву недостатність, інсульт або іншу серцево-судинну подію, ніж жінки...
Встановлено ген, який впливає на чутливість до алкоголю
Оскільки одним з основних факторів ризику алкоголізму є толерантність до алкоголю, дослідники довгий час намагалися зрозуміти генетичні відмінності між людьми, які впливають на їх...